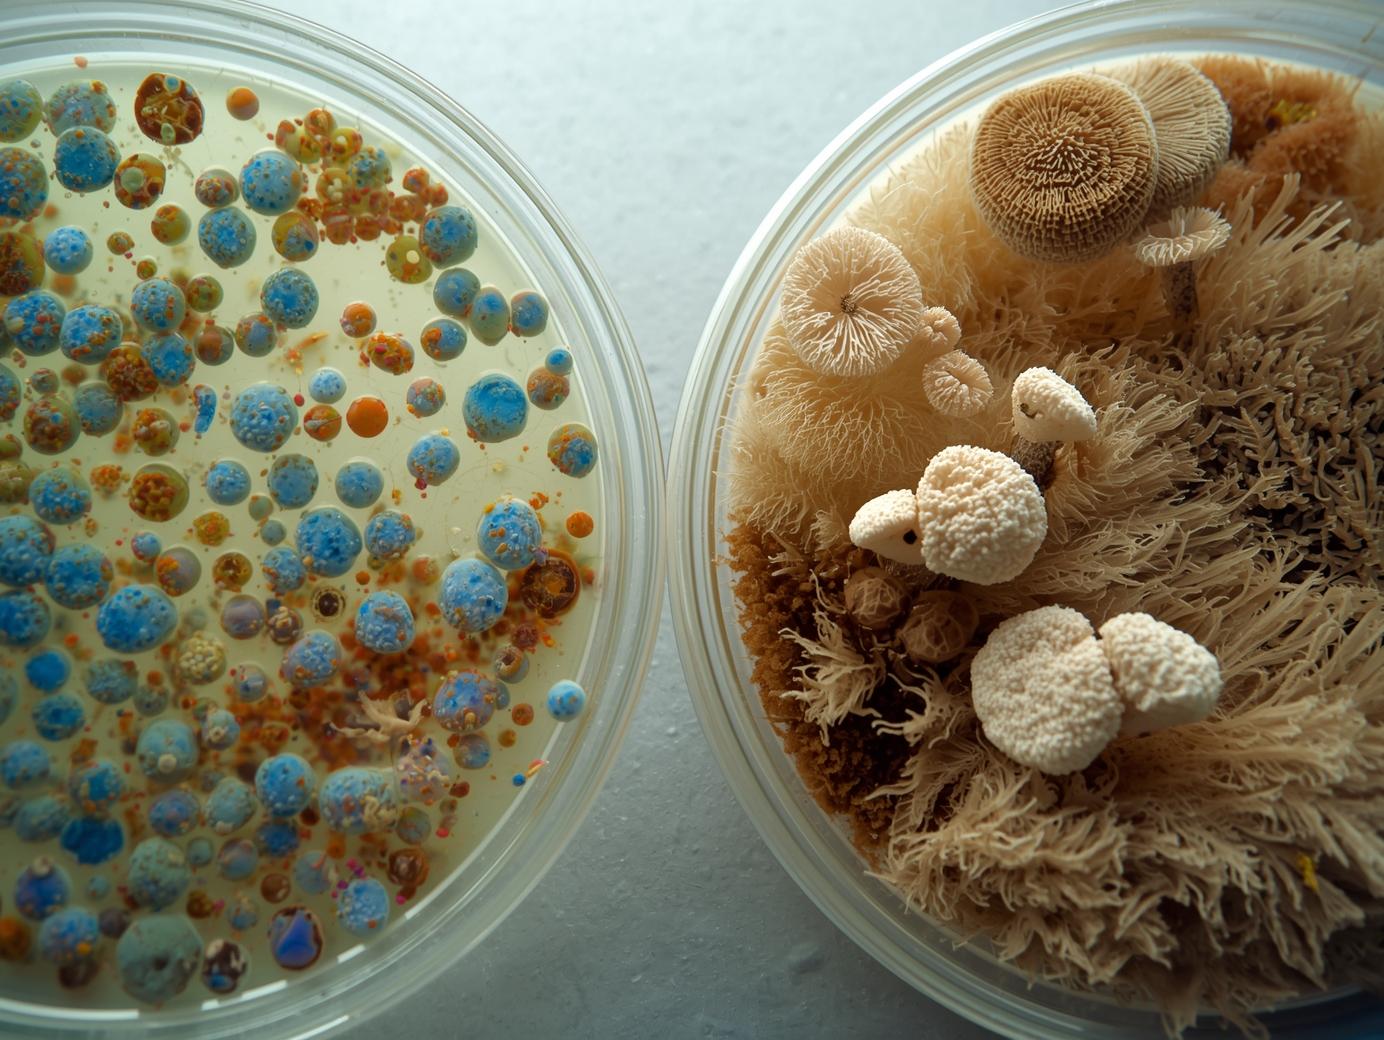

총부유세균은 뒤집고, 부유곰팡이는 똑바로? 배양법이 다른 이유!
“같은 실내공기 시료인데, 왜 하나는 뒤집고 하나는 그대로 둘까?”
실험실에서 자주 하는 질문이죠.
오늘은 부유세균 vs 부유곰팡이, 배양 방향이 다른 이유를 쉽고 확실하게 알려드릴게요 🔬

🦠 1. 총부유세균과 부유곰팡이, 뭐가 다를까?
실내공기질 측정 항목 중 대표적인 미생물 지표가 바로
총부유세균(Total Airborne Bacteria) 과 부유곰팡이(Airborne Fungi) 입니다.
둘 다 공기 중에 떠다니는 미생물을 포집해, 평판배지(petri dish) 에 배양해서 개수를 세죠.
하지만 성질이 달라요 👇
| 구분 | 총부유세균 | 부유곰팡이 |
| 생장속도 | 빠름 (24~48시간 내 발육) | 느림 (3~7일 이상) |
| 수분요구도 | 높음 | 낮음 |
| 온도 적정범위 | 35±1℃ | 25±1℃ |
이 차이가 바로 배양 방향이 달라지는 이유의 핵심이에요.
🧫 2. 총부유세균은 ‘뒤집어서’ 배양하는 이유
총부유세균은 고온·고습 환경에서 빠르게 자라요.
따라서 배양 중에 다음과 같은 문제가 생기기 쉬워요 👇
1️⃣ 응결수(물방울) 발생
인큐베이터 안 온도는 35℃ 전후라, 배지 뚜껑 안쪽에 물방울이 맺힙니다.
이 물방울이 떨어지면 → 세균 콜로니가 번지거나 섞이죠.
2️⃣ 오염 가능성 증가
물이 떨어지면 집락이 뭉쳐서 정확한 콜로니 카운트가 어려워집니다.
👉 그래서 뚜껑이 아래로 가게 뒤집어 배양하면, 응결수가 배지에 떨어지는 걸 방지할 수 있어요.
즉, 정확한 정량분석을 위한 조치입니다.
- 세균 배양 시 응결수 방지 목적
- 정확한 집락 수를 확보하기 위해 ‘뒤집어서’ 배양

🍄 3. 부유곰팡이는 ‘똑바로’ 배양하는 이유
곰팡이는 세균과 달리 상온(25℃)에서 장기간 배양해야 하고,
포자(Spore) 가 가볍게 떠다니는 특성이 있어요.
👉 만약 뒤집어서 배양하면?
곰팡이 포자가 중력 방향으로 이동하며 뚜껑에 붙거나 주변으로 날릴 수 있어요.
또한 곰팡이의 균사체는 위쪽으로 자라기 때문에, 뒤집으면 배양 표면이 눌리거나 오염될 위험이 있습니다.
그래서 부유곰팡이는 뚜껑이 위로 가게 똑바로 배양하는 게 원칙이에요.
- 곰팡이는 포자 비산 방지 목적
- 균사 성장 방향(위쪽) 유지 위해 ‘똑바로’ 배양
⚗️ 4. 실제 실험실에서의 주의점
- 세균·곰팡이 모두 배양 전 시료 수거 후 24시간 내 배양 개시
- 배양 중엔 인큐베이터 문을 자주 열지 않기 (온도 변화로 응결수 생김)
- 배양 후에는 무균대(클린벤치) 에서 집락 관찰 및 카운트
👉 이런 과정을 지켜야 실내공기질 측정값의 신뢰성이 확보된답니다!

결론은!
| 구분 | 총부유세균 | 부유곰팡이 |
| 배양 방향 | 뒤집어서 (뚜껑 아래) | 똑바로 (뚜껑 위) |
| 이유 | 응결수 방지 및 집락 보호 | 포자비산 방지 및 균사 성장 유지 |
“세균은 물방울을 피하려고 뒤집고, 곰팡이는 균사가 눌리지 않게 똑바로 둔다!”
오늘도 감사합니다!
- 가히랩 🧪